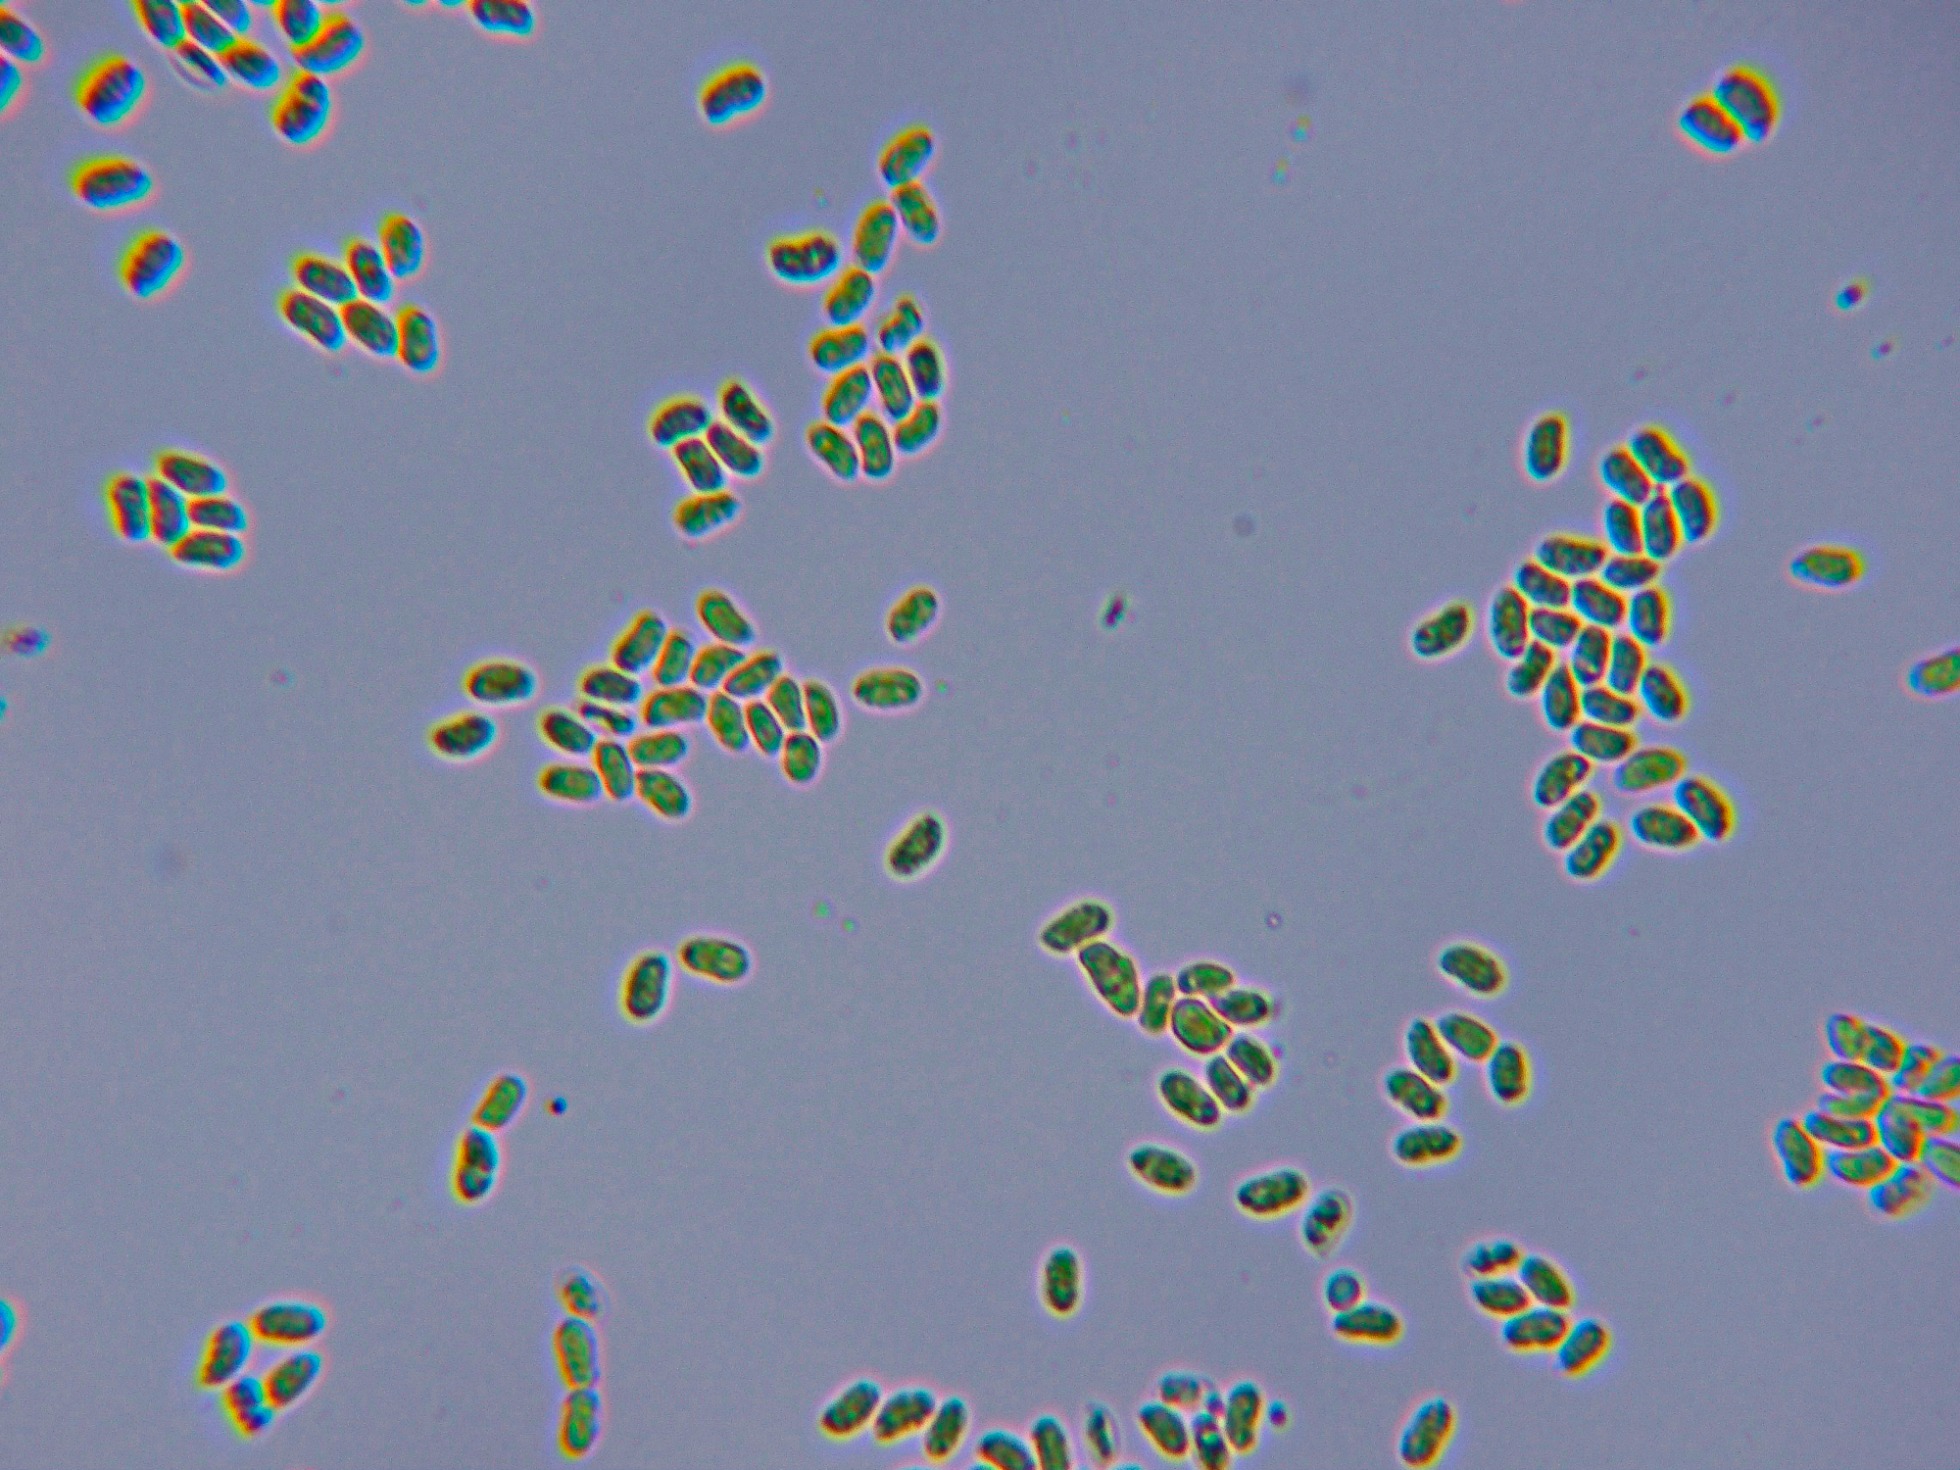

- Foro
- Foros sobre Micología de fungipedia
- Microscopía
- Stereophlebia tuberculata (Berk. & M.A. Curtis) Zmitr.
 Stereophlebia tuberculata (Berk. & M.A. Curtis) Zmitr.
Stereophlebia tuberculata (Berk. & M.A. Curtis) Zmitr.
- Josep Torres
-
 Autor del tema
Autor del tema
- Fuera de línea
- Moderador
-

Menos
Más
- Mensajes: 8746
- Gracias recibidas: 8379
3 años 11 meses antes - 3 años 11 meses antes #107333
por Josep Torres
Hola a tod@s.
Un Corticial de aspecto céreo y granuloso de color crema fotografiado el domingo 24 de Abril, con el borde de crecimento blanquecino y algo plumoso creciendo sobre la superficie de un tronco probablemente de roble, la Phlebia tuberculata actualmente:
Stereophlebia tuberculata (Berk. & M.A. Curtis) Zmitr.
Su superficie a 20 aumentos:
Sistema hifal monomítico con hifas subiculares provistas de gruesas fíbulas y contenido oleoso en su interior. Himenio con abundantes cristales gruesos.
No se observan en el himenio cistidios diferenciados, pero si algunas hifas terminales fusiformes a modo de cistidiolos que no sobresalen de la superficie.
En la sección del himenio se pueden observar unas hifas dispuestas perpendicularmente muy espesas y compactadas.
Basidios de difícil observación, presumiblemente tetraspóricos.
Esporas entre cilíndricas y algo elipsoides, en las que se intuye una apícula lateral, prácticamente hialinas o con tenue contenido en su inerior, inamiloides al Melzer y con unas medidas en agua de:
(4.4) 4.6 - 5.6 (6) × (2.5) 2.8 - 3.2 (3.3) µm
Q = (1.5) 1.6 - 1.9 (2) ; N = 40
Me = 5.1 × 3 µm ; Qe = 1.7
Las esporas en agua:
Las esporas en Reactivo de Melzer:
Agradecer a Jesús Riezu y en especial a Enrique Rubio Dominguez por su gran ayuda en la determinación de la especie.
Saludos a tod@s.
Un Corticial de aspecto céreo y granuloso de color crema fotografiado el domingo 24 de Abril, con el borde de crecimento blanquecino y algo plumoso creciendo sobre la superficie de un tronco probablemente de roble, la Phlebia tuberculata actualmente:
Stereophlebia tuberculata (Berk. & M.A. Curtis) Zmitr.
Su superficie a 20 aumentos:
Sistema hifal monomítico con hifas subiculares provistas de gruesas fíbulas y contenido oleoso en su interior. Himenio con abundantes cristales gruesos.
No se observan en el himenio cistidios diferenciados, pero si algunas hifas terminales fusiformes a modo de cistidiolos que no sobresalen de la superficie.
En la sección del himenio se pueden observar unas hifas dispuestas perpendicularmente muy espesas y compactadas.
Basidios de difícil observación, presumiblemente tetraspóricos.
Esporas entre cilíndricas y algo elipsoides, en las que se intuye una apícula lateral, prácticamente hialinas o con tenue contenido en su inerior, inamiloides al Melzer y con unas medidas en agua de:
(4.4) 4.6 - 5.6 (6) × (2.5) 2.8 - 3.2 (3.3) µm
Q = (1.5) 1.6 - 1.9 (2) ; N = 40
Me = 5.1 × 3 µm ; Qe = 1.7
Las esporas en agua:
Las esporas en Reactivo de Melzer:
Agradecer a Jesús Riezu y en especial a Enrique Rubio Dominguez por su gran ayuda en la determinación de la especie.
Saludos a tod@s.
Adjuntos:
Última Edición: 3 años 11 meses antes por Josep Torres. Razón: Una falta de ortografía
El siguiente usuario dijo gracias: Juan Andrés Román, Juan
Por favor, Identificarse para unirse a la conversación.
- Juan Andrés Román
-

- Fuera de línea
- Spammer
-

Menos
Más
- Mensajes: 2558
- Gracias recibidas: 2756
3 años 11 meses antes #107350
por Juan Andrés Román
Respuesta de Juan Andrés Román sobre el tema Stereophlebia tuberculata (Berk. & M.A. Curtis) Zmitr.
Buen aporte Josep................. Saludos.
El siguiente usuario dijo gracias: Josep Torres
Por favor, Identificarse para unirse a la conversación.
- Josep Torres
-
 Autor del tema
Autor del tema
- Fuera de línea
- Moderador
-

Menos
Más
- Mensajes: 8746
- Gracias recibidas: 8379
3 años 11 meses antes #107353
por Josep Torres
Respuesta de Josep Torres sobre el tema Stereophlebia tuberculata (Berk. & M.A. Curtis) Zmitr.
El siguiente usuario dijo gracias: Juan Andrés Román
Por favor, Identificarse para unirse a la conversación.
- Foro
- Foros sobre Micología de fungipedia
- Microscopía
- Stereophlebia tuberculata (Berk. & M.A. Curtis) Zmitr.
Tiempo de carga de la página: 0.160 segundos

Foro de micología